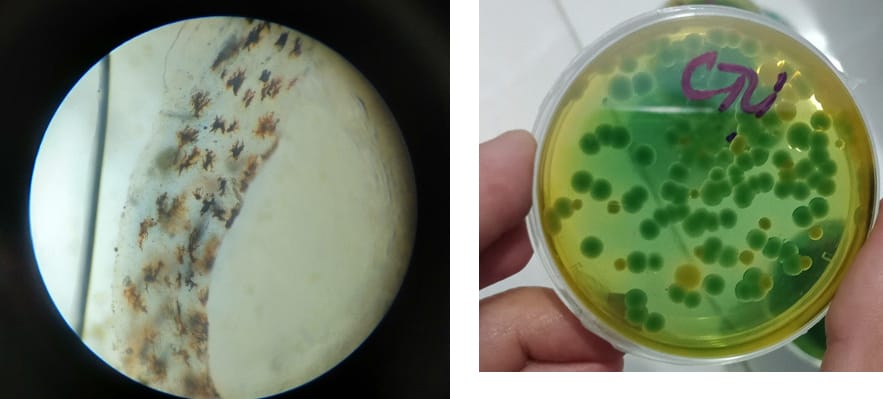

MEN RUỘT THẢO DƯỢC HERBAL BIOTIC
Giải pháp số 1 cho phòng và trị bệnh phân trắng và đường ruột trên Tôm
MEN RUỘT THẢO DƯỢC CHO TÔM HERBAL BIOTIC là sản phẩm men đường ruột thảo dược đặc biệt. Được sản xuất từ ba thành phần chính : Cao Mộc Hoa Trắng, Xuyên Tâm Liên và công nghệ vách tế bào Immunevets® . Đây là những loại chiết xuất thảo dược chuyên sử dụng cho đường ruột của Tôm nổi bật với khả năng hoạt động như kháng sinh tự nhiên, giúp tiêu diệt ký sinh trùng, vi khuẩn và virus gây ra các bệnh về đường ruột như lỏng ruột, đứt ruột, xoắn đường ruột và đặc biệt là bệnh phân trắng trên tôm.
1.Thành phần chính men ruột thảo dược HEBAL BIOTIC :
– Dược liệu Mộc Hoa Trắng
– Dược liệu Xuyên Tâm Liên
– Nguyên liệu Immunevets®
1.1. Cao Mộc Hoa Trắng
Cao Mộc Hoa Trắng được chiết xuất từ cây mộc hoa trắng. Sản phẩm có dạng bột hoặc lỏng màu nâu, mùi thơm đặc trưng. Các tác dụng nổi bật của Cao Mộc Hoa Trắng trong điều trị bệnh đường ruột trên tôm bao gồm:
- Kháng khuẩn: Giúp hạn chế sự phát triển của vi khuẩn có hại trong đường ruột của tôm.
- Chống oxy hóa: Bảo vệ tế bào khỏi tổn thương, từ đó nâng cao sức khỏe tổng thể.
- Cải thiện tiêu hóa: Tăng cường khả năng tiêu hóa và hấp thụ dinh dưỡng.

1.2. Cao Xuyên Tâm Liên và tác dụng lên Tôm
Cao Xuyên Tâm Liên thường được sử dụng trong Đông y để thanh nhiệt giải độc và điều trị các bệnh về hô hấp. Đối với tôm, các tác dụng của Cao Xuyên Tâm Liên bao gồm:
- Tăng cường hệ miễn dịch: Giúp tôm chống lại các bệnh nhiễm trùng, duy trì sức khỏe đường tiêu hóa.
- Chống viêm: Giảm thiểu viêm nhiễm trong hệ tiêu hóa, hỗ trợ quá trình tiêu hóa.
- Tăng cường hấp thụ dinh dưỡng: Cải thiện khả năng hấp thụ thức ăn, giúp tôm phát triển khỏe mạnh hơn.

1.3. Immunevets®
Immunevets® là chế phẩm sinh học được ứng dụng công nghệ tách vách tế bào từ các chủng lợi khuẩn nhằm tăng cường hệ miễn dịch cho vật nuôi. Thành phần của Immunevets® gồm có 2 thành phần : Vách tế bào Lactobacillus rahamnosus & Beta Glucan (1,3/1,6) chiết xuất từ nấm men Saccharomyces cerevisiae đem lại tác động kép cho hệ miễn dịch của Tôm.
- Tăng cường hệ miễn dịch: Giúp tôm tăng khả năng chống lại các bệnh nhiễm trùng, từ đó cải thiện sức khỏe tổng thể.
- Cải thiện sức đề kháng: Thành phần của Immunevets® giúp nâng cao sức đề kháng của tôm đối với các tác nhân gây bệnh.
- Hỗ trợ tiêu hóa: Tăng cường hoạt động của hệ vi sinh vật có lợi trong đường ruột, từ đó cải thiện quá trình tiêu hóa và hấp thụ dinh dưỡng.
- Chống oxy hóa: Giúp bảo vệ tế bào tôm khỏi tổn thương, hỗ trợ phục hồi nhanh chóng sau khi bị stress.
- Ổn định môi trường nuôi: Giảm thiểu sự phát triển của vi khuẩn có hại, góp phần cải thiện chất lượng nước trong ao nuôi.

2. Công dụng của men ruột thảo dược HEBAL BIOTIC
- Phòng ngừa và hỗ trợ điều trị bệnh phân trắng: Tiêu diệt ký sinh trùng, vi khuẩn và virus trong đường ruột.
- Cải thiện chức năng trao đổi chất: Tăng cường khả năng tiêu hóa và hấp thụ chất dinh dưỡng.
- Ổn định hệ vi sinh vật đường ruột: Giúp tôm hấp thụ tốt hơn các chất dinh dưỡng.
- Tăng cường sức đề kháng: Nhờ vào công nghệ Immunevets, sản phẩm hỗ trợ cải thiện hệ miễn dịch cho tôm.
3. Hướng dẫn sử dụng men ruột thảo dược HEBAL BIOTIC
- Trộn vào thức ăn: 10ml/kg thức ăn, áp dụng liên tục trong suốt thời gian nuôi.
- Tạt ao: 1 lít cho 1.000m³ nước.
- Trong trường hợp trị bệnh phân trắng, đường ruột : Tăng gấp đôi liều lượng, giảm 50% lượng thức ăn, duy trì trong 5-7 ngày.
THẢO DƯỢC CHO TÔM HERBAL BIOTIC không chỉ là giải pháp hiệu quả cho bệnh phân trắng, đường ruột ở tôm mà còn góp phần bảo vệ và nâng cao sức khỏe tổng thể cho vật nuôi. Sử dụng HERBAL BIOTIC với các sản phẩm Men đường ruột PROBIOTIC & PROZYME sẽ góp phần bảo vệ đường ruột tối ưu cho Tôm của Bạn

Xem thêm sản phẩm sử dụng chung với HERBAL BIOTIC : Men đường ruột PROBIOTIC và Enzym chuyên biệt cho đường ruột của Tôm PROZYME
Xem thêm sản phẩm Thảo Dược Bổ Gan cho Tôm HERBWAY















Đánh giá
Chưa có đánh giá nào.